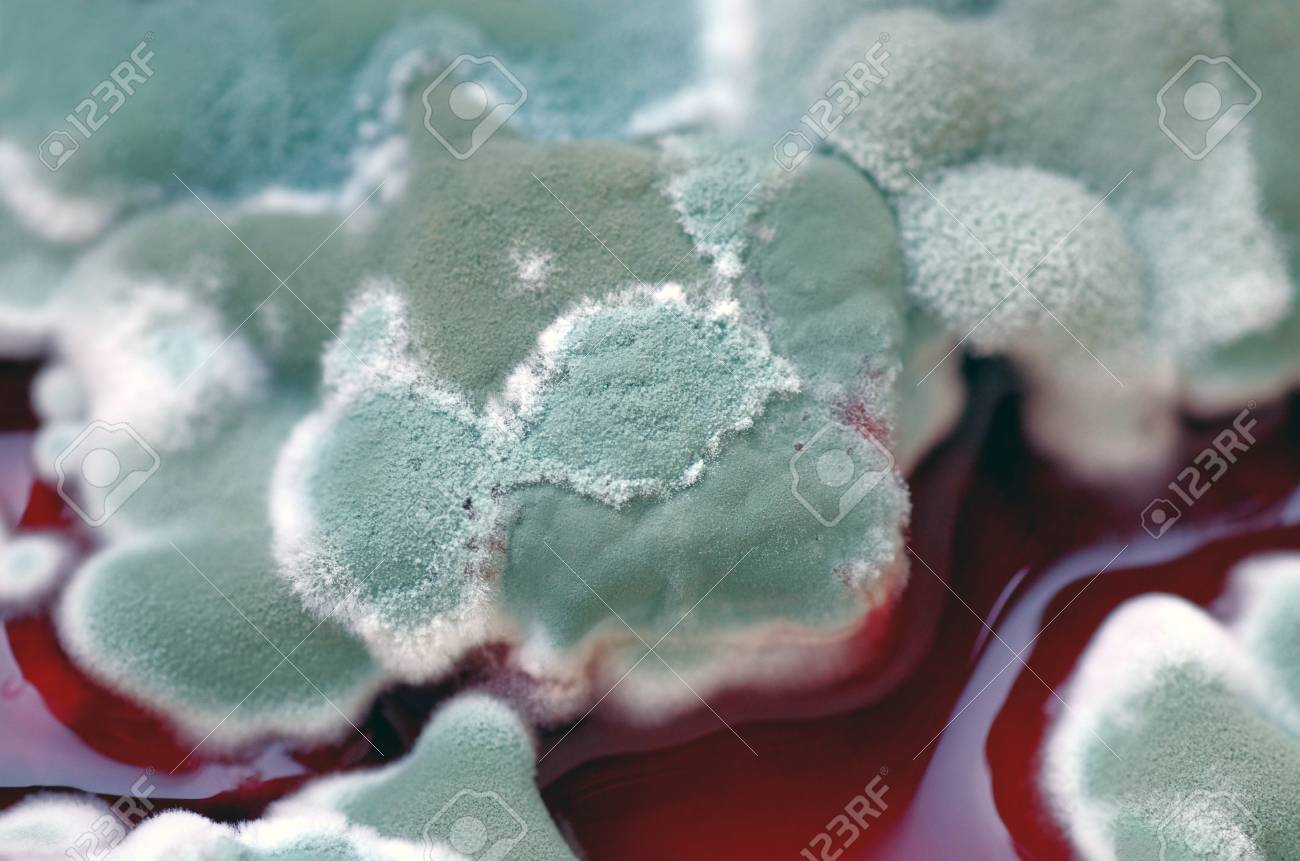
etiam-dictum-ipsum-a-felis

Download
Close
Автор:
id:
Ключевые слова:
abstract, allergy, asexual, backdrop, background, biological, biology, closeup, colonies, disease, food, fungal, fungi, fungus, growth, health, infection, life, liquid, macro, micro, microbe, microscopic, mildew, mold, mushroom, organic, plant, proliferation, red, replication, reproduction, rotten, round, scientific, skin, spoiled, spore, spread, unhealthy, white, yeast,





